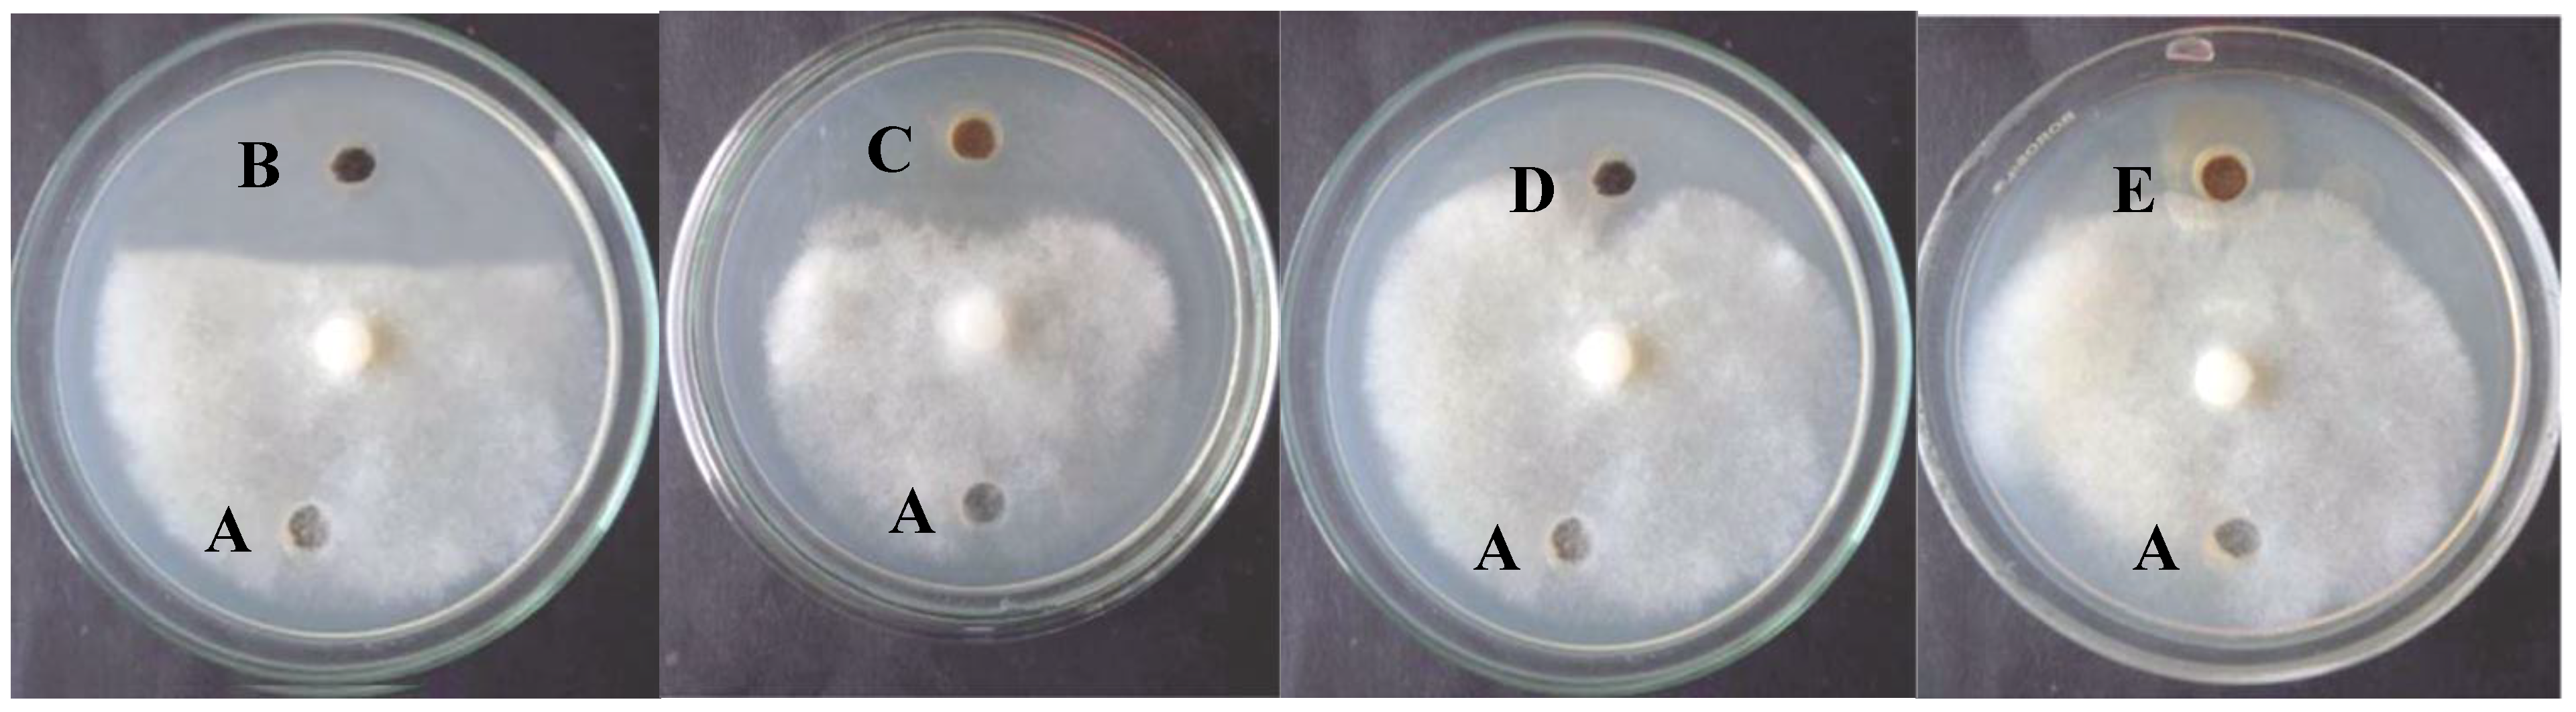
Plants 10 01858 g006

Mycogenic Nano-Complex for Plant Growth Promotion and Bio-Control of Pythium aphanidermatum
Abstract
1. Introduction
2. Results and Discussion
Mass Spectra
3. Materials and Methods
3.1. Materials
3.2. Instrumentation
3.3. Synthesis of the Schiff Base Ligand
3.4. Studied Micro-Organisms
3.5. Preparation of Biomass of Trichoderma Longibrachiatum (MT550032)
3.6. Pathogenicity Tests of Nano Metal Complex against Seedling and Germination of Seeds
3.7. Biosynthesis of the Nano-Metal Complex
3.8. Bioassay of Nano-Metal Complex against Pythium aphanidermatum
3.9. Evaluation of Nano-Metal Complex as Antifungal Activity and Plant Growth Promotion in Pot Experiment
4. Conclusions
Author Contributions
Funding
Institutional Review Board Statement
Informed Consent Statement
Data Availability Statement
Acknowledgments
Conflicts of Interest
References
- Harman, G.E. Trichoderma—Not just for biocontrol anymore. Phytoparasitica 2011, 39, 103–108. [Google Scholar] [CrossRef]
- FRAC. Fungicide Resistance Action Committee. Resistance Tables Benz. 2016. Available online: http://www.frac.info/docs/default-source/expert-fora/2004-06-11resistance_tables_benz.pdf (accessed on 25 July 2021).
- Guilger-Casagrande, M.; de Lima, R. Synthesis of silver nanoparticles mediated by fungi. A review. Front. Bioeng. Biotechnol. 2019, 7, 287. [Google Scholar] [CrossRef] [PubMed]
- Vijayakumar, M.; Priya, K.; Nancy, F.T.; Noorlidah, A.; Ahmed, A.B.A. Biosynthesis, characterization and anti-bacterial effect of plant-mediated silver nanoparticles using Artemisia nilagirica. Ind. Crops Prod. 2013, 41, 235–240. [Google Scholar] [CrossRef]
- Peter, L.; Silambarasan, S.; Abraham, J. Ecofriendly synthesis of silver nanoparticles from commercially available plant powders and their antibacterial properties. Sci. Iran. 2013, 20, 1049–1054. [Google Scholar]
- Peter, L.; Sivagnanam, S.; Abraham, J. Synthesis of silver nanoparticles using plants extract and analysis of their antimicrobial property. J. Saudi Chem. Soc. 2015, 19, 311–317. [Google Scholar]
- Ingle, A.; Rai, M.; Gade, A.; Bawaskar, M. Fusarium solani: A novel biological agent for the extracellular synthesis of silver nanoparticles. J. Nanoparticle Res. 2009, 11, 2079–2085. [Google Scholar] [CrossRef]
- Neveen-Mohamed, K. Biogenic silver nanoparticles by Aspergillus terreus as a powerful nanoweapon against Aspergillus fumigates. Afr. J. Microbiol. Res. 2014, 7, 5645–5651. [Google Scholar] [CrossRef]
- Husseiny, M.I.; Abd El-Aziz, M.; Badr, Y.; Mahmoud, M.A. Biosynthesis of gold nanoparticles using Pseudomonas aeruginosa. Spectrochim. Acta A Mol. Biomol. Spectrosc. 2006, 67, 1003–1006. [Google Scholar] [CrossRef]
- El-Shanshoury, A.R.; ElSilk, S.E.; Ebeid, M.E. Extracellular biosynthesis of silver nanoparticles using Escherichia coli ATCC 8739, Bacillus subtilis ATCC 6633, and Streptococcus thermophilus ESh1 and their antimicrobial activities. ISRN Nanotechnol. 2011, 2011, 385480. [Google Scholar] [CrossRef]
- Dueke-Eze, C.U.; Fasina, T.M.; Idika, N. Synthesis, electronic spectra and inhibitory study of some Salicylaldehyde Schiff bases of 2-aminopyridine. Afr. J. Pure Appl. Chem. 2011, 5, 13–18. [Google Scholar]
- Yadav, M. Synthesis, Characterization, and Biological Activity of Some Transition Metal Complexes of N-Benzoyl-N′-2-thiophenethiocarbohydrazide. Int. J. Inorg. Chem. 2012, 2012, 269497. [Google Scholar] [CrossRef][Green Version]
- Fasina, T.M.; Ogundele, O.O.; Ayeni, I. Synthesis and biological properties of N2O2 Schiff bases derived from o-phenylenediamine and substituted salicylaldehydes. J. Chem. Pharm. Res. 2014, 6, 816–819. [Google Scholar]
- Gomathi, V.; Selvameena, R.; Valarmathy, G. Synthesis, Spectroscopic, Electrochemical and Biological studies of Schiff Base Complexes of Some 3d transition metals derived from 2-aminophenol and 2-hydroxynaphthaldehyde. Indian J. Appl. Res. 2013, 3, 51–53. [Google Scholar] [CrossRef]
- Aliyu, H.N.; Bello, I. Synthesis and Characterization of Diaquo Bis (N-Histidyl -2, 4-Pentanedionato) Copper (II) Complex. Biokemistri 2010, 22, 105–110. [Google Scholar]
- EL-Hashash, M.A.; Essawy, A.; Fawzy, A.S. Synthesis and antimicrobial activity of some novel heterocyclic candidates via michael addition involving 4-(4-acetamidophenyl)-4-oxobut-2-enoic acid. Adv. Chem. 2014, 2014, 619749. [Google Scholar] [CrossRef]
- Kumar, M.; Saxena, P.N. Transition Metal Complexes of 5-bromo Salicylaldehyde-2-furoic acid hydrazide; Synthesis and Characterisation. Orient. J. Chem. 2012, 28, 1927–1931. [Google Scholar] [CrossRef][Green Version]
- Karekal, M.R.; Biradar, V.; Bennikallu Hire Mathada, M. Synthesis, Characterization, Antimicrobial, DNA Cleavage, and Antioxidant Studies of Some Metal Complexes Derived from Schiff Base Containing Indole and Quinoline Moieties. Bioinorg. Chem. Appl. 2013, 2013, 315972. [Google Scholar] [CrossRef]
- Khandelwal, A.; Agrawal, M.; Lamba, S.; Baswal, G. Synthesis And Characterization Of Mixed Ligand Complexes Of Mn(iii) With 5-bromosalicylaldehyde And 2-hydroxyaryl Carbonyl Compounds Or Âdiketones. Wkly. Sci. Res. J. 2013, 2321, 7871. [Google Scholar]
- Ahmed, R.M.; Yousif, E.I.; Hasan, H.A.; Al-Jeboori, M.J. Metal Complexes of Macrocyclic Schiff-Base Ligand: Preparation, Characterisation, and Biological Activity. Sci. World J. 2013, 2013, 289805. [Google Scholar] [CrossRef]
- Mohamed, G.G.; Zayed, M.A.; Abdallah, S.M. Synthesis, Characterization and Crystal Structure of a New Schiff Base Ligand from a Bis(Thiazoline) Template and Hydrolytic Cleavage of the Imine Bond Induced by a Co(II) Cation. J. Mol. Struct. 2010, 979, 65. [Google Scholar]
- Mohebbi, S.; Bakhshi, B. Electrochemical and spectral behavior of mononuclear oxo-vanadium(IV)salicyldiimine complexes. J. Coord. Chem. 2008, 61, 2615. [Google Scholar] [CrossRef]
- Mandegani, Z.; Asadi, M.; Asadi, Z.; Mohajeri, A.; Iranpoor, N.; Omidvar, A. A nano tetraimine Pd(0) complex: Synthesis, characterization, computational studies and catalytic applications in the Heck–Mizoroki reaction in water. Green Chem. 2015, 17, 3326–3337. [Google Scholar] [CrossRef]
- Khan, A.U.; Malik, N.; Khan, M.; Cho, M.H.; Khan, M.M. Fungi-assisted silver nanoparticle synthesis and their applications. Bioprocess Biosyst. Eng. 2017, 41, 1–20. [Google Scholar] [CrossRef] [PubMed]
- Simões, M.F.; Ottoni, C.A.; Antunes, A. Biogenic metal nanoparticles: A new approach to detect life on Mars? Life 2020, 10, 28. [Google Scholar] [CrossRef]
- Ovais, M.; Khalil, A.T.; Ayaz, M.; Ahmad, I.; Nethi, S.K.; Mukherjee, S. Biosynthesis of metal nanoparticles via microbial enzymes: A mechanistic approach. Int. J. Mol. Sci. 2018, 19, 4100. [Google Scholar] [CrossRef]
- Zhao, X.; Zhou, L.; Rajoka, M.S.R.; Yan, L.; Jiang, C.; Shao, D.; Zhu, J.; Shi, J.; Huang, Q.; Yang, H.; et al. Fungal silver nanoparticles: Synthesis, application and challenges. Crit. Rev. Biotechnol. 2018, 38, 817–835. [Google Scholar] [CrossRef] [PubMed]
- Khandel, P.; Shahi, S.K. Mycogenic nanoparticles and their bio-prospective applications: Current status and future challenges. J. Nanostruct. Chem. 2018, 8, 369–391. [Google Scholar] [CrossRef]
- Yadav, A.; Verma, A.; Yadav, K. Fungal nanoparticles: An emerging tool in medical biology. In Advances and Applications through Fungal Nanobiotechnology; Springer: Cham, Switzerland, 2016; pp. 213–240. [Google Scholar]
- Ragab, M.M.; Abada, K.A.; Abd-El-Moneim, L.M.; Abo-Shosha, Y.Z. Effect of different mixtures of some bioagents and Rhizobium phaseoli on bean damping-off under field condition. Inter. J. Sci. Eng. Res. 2015, 6, 1099–1106. [Google Scholar]
- Ahmed, G.A. Efficiency of some antioxidants and bioagents in controlling Rhizoctonia damping-off of snap bean. Middle East J. App. Sci. 2016, 6, 748–758. [Google Scholar]
- El-Sayed, S.A. Management of Damping-Off and Root Rot Diseases of Faba bean by Bioproducts and Inducer Resistance Chemicals. Egypt. J. Phytopathol. 2017, 45, 135–156. [Google Scholar] [CrossRef]
- Kamala, T.; Indira, S. Evaluation of indigenous Trichoderma isolates from Manipur as biocontrol agent against Pythium aphanidermatum on common beans. 3 Biotech 2011, 1, 217–225. [Google Scholar] [CrossRef]
- El-kafrawy, A.A. Biological control of bean damping-off caused by Rhizoctonia solani. Egypt J. Agric. Res. 2010, 80, 57–70. [Google Scholar]
- Gonzalez, R.M.; Castellanos, L.G.; Rames, M.F.; Perez, G.G. Effectiveness of Trichoderma spp. for the control of seed and soil pathogenic fungi in bean crop. Fitosanidad 2005, 9, 37–41. [Google Scholar]
- Malik, G.; Dawar, S.; Sattar, A.; Dawar, V. Efficacy of Trichoderma harzianum after multiplication on different substrates in the control of root rot fungi. Int. J. Biol. Biotechnol. 2005, 2, 237–242. [Google Scholar]
- Yadav, A.; Kon, K.; Kratosova, G.; Duran, N.; Ingle, A.P.; Rai, M. Fungi as ancient mycosystem for the synthesis of metal nanoparticles: Progress and key aspects of research. Biotechnol. Lett. 2015, 37, 2099–2120. [Google Scholar] [CrossRef] [PubMed]
- Prameela Devi, T.; Kulanthaivel, S.; Kamil, D.; Borah, J.L.; Prabhakaran, N.; Srinivasa, N. Biosynthesis of silver nanoparticles from Trichoderma species. Indian J. Exp. Biol. 2013, 51, 543–547. [Google Scholar]
- Singh, R.; Nawale, L.U.; Arkile, M.; Shedbalkar, U.U.; Wadhwani, S.A.; Sarkar, D.; Chopade, B.A. Chemical and biological metal nanoparticles as antimycobacterial agents: Acomparative study. Int. J. Antimicrob. Agents 2015, 46, 183–188. [Google Scholar] [CrossRef] [PubMed]
- Minakshi, P.; Ghosh, M.; Brar, B.; Kumar, R.; Lambe, U.P.; Ranjan, K.; Manoj, J.; Prasad, G. Nano-antimicrobials: A new paradigm for combating mycobacterial resistance. Curr. Pharm. Des. 2019, 25, 1554–1579. [Google Scholar] [CrossRef]
- Mourato, A.; Gadanho, M.; Lino, A.R.; Tenreiro, R. Biosynthesis of crystalline silver and gold nanoparticles by extremophilic yeasts. Bioinorg. Chem. Appl. 2011, 2011, 546074. [Google Scholar] [CrossRef]
- Taha, R.H. Preparation, Spectroscopic Characterization, DNA Cleavage, Antimicrobial and Antitumor Investigations of Nickel and Uranyl Schiff Base Complexes in Bulk and Nano size. Curr. Sci. Int. 2018, 4, 684–700. [Google Scholar]

| Compd. No. Empirical Formula | M.P. (°C) | Color (Yield %) | (%) Found (Calcd.) Λm * | |||
|---|---|---|---|---|---|---|
| C | H | N | ||||
| Free Ligand(L) C20H14Br2N2O2 | 200 | Dark Yellow (90.20) | 36.89 (50.64) | 2.93 (2.98) | 12.01 (5.91) | - |
| (5)[(Zn)(L)](NO3)2 C20H14Br2N4O8Zn Nano Complex | >350 | Dark Yellow (85.79) | 33.59 (33.90) | 1.95 (2.00) | 7.86 (7.91) | 11.25 |
| Compd. No. | δph | δCH=N | δOH |
|---|---|---|---|
| L | 6.465–8.175 | 9.335 | 11.247 |
| Zn Nano Complex | 6.451–7.684 | 8.252 | 10.210 |
| Compd.No. | ʋO-H (Phenolic) | ʋCH=N (Azomethine) | ʋC-O (Phenolic) | ʋM-O | ʋM-N | Additional Bands |
|---|---|---|---|---|---|---|
| L | 3456 | 1620 | 1290 | - | - | - |
| Zn-nanocomplex | 3401 | 1532 | 1240 | 550 | 515 | 1401, 1372, 1025 (coord.NO3) |
| Compd. No. | μeff (B.M.) | Absorption Bands (nm) | ||
|---|---|---|---|---|
| п-п* | n-п* | d-d Transition | ||
| L | - | 265 | 339 | - |
| Zn-nano complex | Diamagnetic | 276 | 323 | - |
| Pythium spp. | Diameter of Inhibition Zone (mm) | ||||
|---|---|---|---|---|---|
| P. aphanidermatum | Positive Control (Metalaxyl) | Negative Control (Sterile Distilled H2O) | Nano Metal Complex (20 ppm) | Nano Metal Complex (15 ppm) | Nano Metal Complex (10 ppm) |
| 3.4 * ± 0.2 ** | 0 | 31 ± 0.4 | 20 ± 0.13 | 11 ± 0.41 | |
| Treatment | Germination % after 48 h | Germination % after 72 h | Length (mm) | |
|---|---|---|---|---|
| Shoot | Root | |||
| Control | 73.33 | 86.6 | 130 | 69.5 |
| Nano-metal complex “10 ppm” | 73.33 | 90 | 150 | 81.8 |
| Nano-metal complex “15 ppm” | 86.67 | 96.6 | 180 | 95.2 |
| Nano-metal complex “20 ppm” | 86.67 | 100 | 180 | 96.5 |
Publisher’s Note: MDPI stays neutral with regard to jurisdictional claims in published maps and institutional affiliations. |
© 2021 by the authors. Licensee MDPI, Basel, Switzerland. This article is an open access article distributed under the terms and conditions of the Creative Commons Attribution (CC BY) license (https://creativecommons.org/licenses/by/4.0/).
Share and Cite
Moustafa, S.M.N.; Taha, R.H. Mycogenic Nano-Complex for Plant Growth Promotion and Bio-Control of Pythium aphanidermatum. Plants 2021, 10, 1858. https://doi.org/10.3390/plants10091858
Moustafa SMN, Taha RH. Mycogenic Nano-Complex for Plant Growth Promotion and Bio-Control of Pythium aphanidermatum. Plants. 2021; 10(9):1858. https://doi.org/10.3390/plants10091858
Chicago/Turabian StyleMoustafa, Shaima M.N., and Rania H. Taha. 2021. "Mycogenic Nano-Complex for Plant Growth Promotion and Bio-Control of Pythium aphanidermatum" Plants 10, no. 9: 1858. https://doi.org/10.3390/plants10091858
APA StyleMoustafa, S. M. N., & Taha, R. H. (2021). Mycogenic Nano-Complex for Plant Growth Promotion and Bio-Control of Pythium aphanidermatum. Plants, 10(9), 1858. https://doi.org/10.3390/plants10091858






